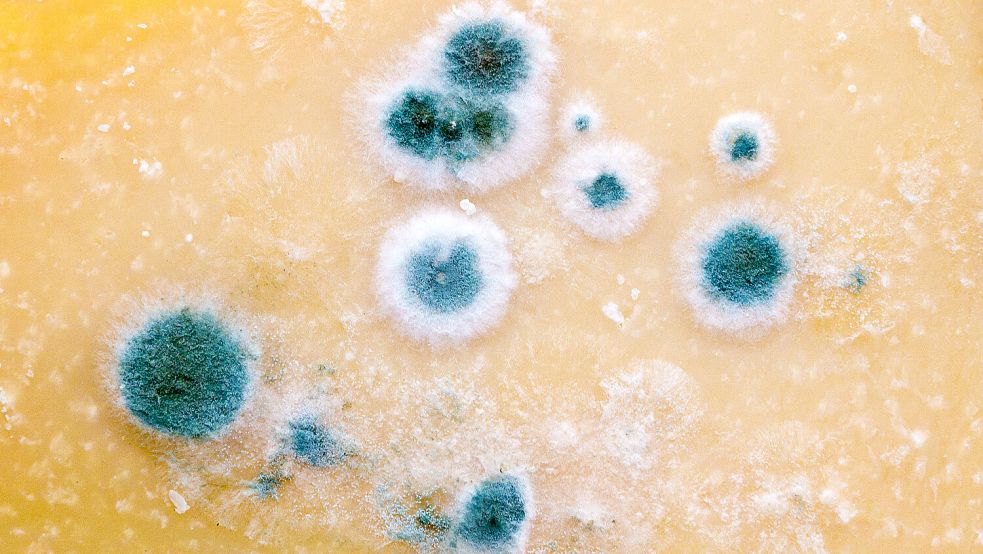

Säuberung mit Gasmasken Laden des Käsekönigs – Fleisch und Käse waren total vergammelt

Vergammelter und verschimmelter Käse lagerte in dem Geschäft, das Marco D. eröffnet hatte - und nach kurzer Zeit inklusive ungekühlter Ware zurückließ. Symbolfoto: Fälchle/stock.adobe.com
Im niederländischen Ijmuiden hatte der als Käsekönig bekannte Betrüger Marco D. einen Feinkostladen nach kurzer Zeit verlassen – inklusive ungekühlter Ware. Diese musste nun aus dem Laden beseitigt werden.
Lesedauer des Artikels: ca. 3 Minuten
Jetzt Artikel freischalten
Schnell bestellt – jederzeit kündbar.
- Voller Zugriff auf www.oz-online.de
- 700+ neue Artikel pro Woche
- OZ-App inklusive
3 Monate je
1€
statt 9,90 €
Du hast bereits ein OZ-Abo? Super!
Weitere Abo-Modelle